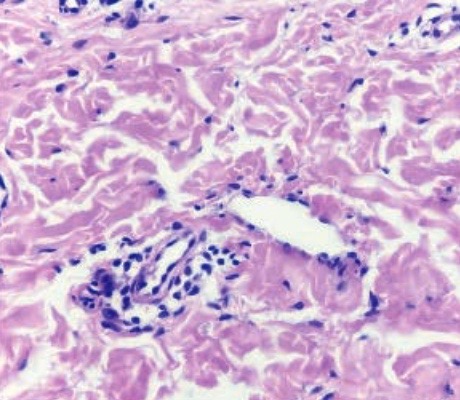

FOR AUTHORS
Search
Search Results
##search.searchResults.foundPlural##
-
Exploring adult-onset actinic prurigo in Thailand
963PDF: 627HTML: 85 -
The humanistic burden of atopic dermatitis in Greece: a cross-sectional study
813PDF: 390SUPPLEMENTARY MATERIAL: 32HTML: 5 -
Skin-limited Langerhans cell histiocytosis in an adult
3309PDF: 644HTML: 14 -
Telangiectasia Macularis Eruptiva Perstans: more than skin deep
11697PDF: 2220HTML: 2302 -
Isolated cutaneous myeloid sarcoma preceding acute myeloid leukemia: a case report and literature review
1052PDF: 509SUPPLEMENTARY MATERIAL: 199HTML: 84 -
Flagellate dermatitis following consumption of shiitake mushroom
1701PDF: 827HTML: 1357 -